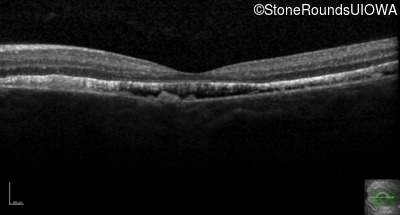
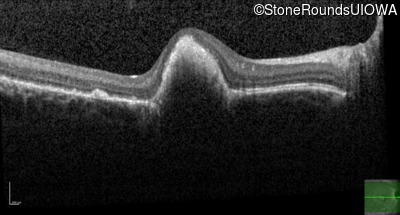
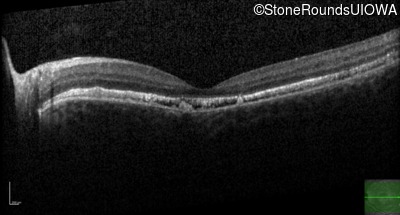
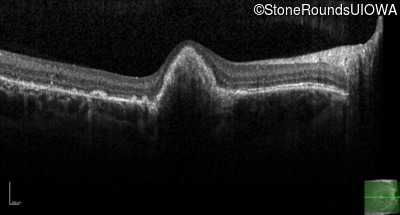
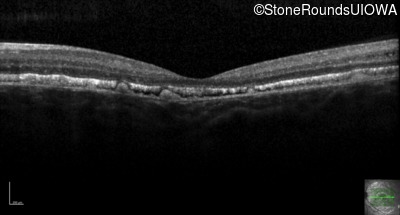
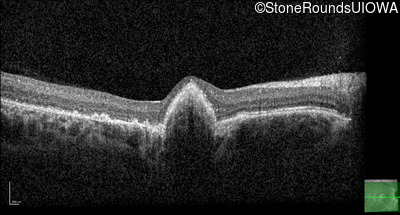
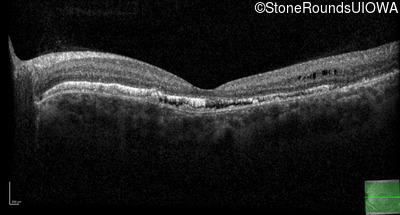

Case
SR419
Student Mode
Best Disease (IIB)
Female
Female
Hidden
SR419
Student Mode
Best Disease (IIB)
Female
Female
Highlighted Images
| Age at visit: 14 years | OD | OS |
|---|---|
History
This 15 year old girl came to medical attention during a routine athletic vision screening when the acuity in her right eye was observed to be abnormal.
| Age at visit: 14 years |
| OD | OS | ||
|---|---|---|---|
| OD | OS | ||
|---|---|---|---|
| OD | OS | ||
|---|---|---|---|
| Age at visit: 19 years |
| OD | OS | ||
|---|---|---|---|
| OD | OS | ||
|---|---|---|---|
Diagnosis & molecular findings
| Disease | Gene | Allele 1 variant(s) | Allele 2 variant(s) | Inheritance mode |
|---|---|---|---|---|
| Best Disease | BEST1 | Asp228Glu GAC>GAG | Asn259 ins2aacAA | AR |
Disease:
Gene:
Allele 1:
Asp228Glu GAC>GAG
Allele 2:
Asn259 ins2aacAA
Inheritance:
AR